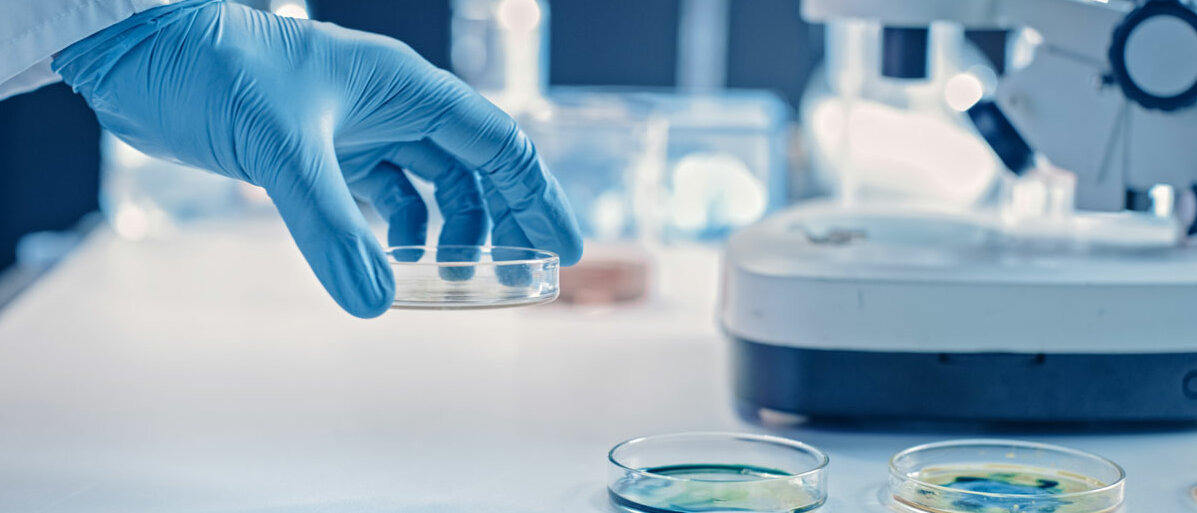
Petrischale Labor

Virulenz | Forschung
ENTTARNT! WIE ZUCKER BAKTERIEN AUSFINDIG MACHT
Seite 1/1 2 Minuten
Es gibt verschiedene Bakterienarten, die im menschlichen Körper oder auf der Haut leben. Viele von ihnen sind harmlos, andere potenziell gefährlich. Professor Micha Fridman von der Tel Aviv University erklärt: „Solange der Körper nicht geschwächt ist, zeigen sie kein opportunistisches Verhalten. Sobald sich die Situation aber ändert, können die Bakterien pathogen werden, sich also ausbreiten und das System infizieren.“ Daneben existieren Bakterien, die immer krankheitserregend sind. Die krankmachende Wirkung auf einen Organismus wird mit dem Begriff der Virulenz beschrieben. Dafür verantwortlich sind bestimmte sogenannte Virulenzfaktoren wie Eiweiße, Zucker oder toxische Moleküle, die ein Bakterium produziert.
Leider geben Bakterien nicht preis, wie virulent sie sind. Doch wie kann man die potenziell krankmachenden Bakterien von den harmlosen unterscheiden? Um diese Frage zu beantworten, haben sich seine Arbeitsgruppe und die Gruppe um Chemiker Professor Daniel B. Werz aus Braunschweig zusammengetan. Die Idee: Das Bakterium nimmt einen spezifischen Zucker auf und lässt sich dadurch enttarnen. Mit einer Forschungsarbeit konnten die Wissenschaftler*innen ihre Vermutung bestätigen.
Dafür haben sich beide Teams aufgeteilt: In Braunschweig tüftelten Professor Werz und seine Kollegen einen modifizierten Zucker aus. Professor Fridman erforschte die biologischen Zusammenhänge von Zucker und Bakterien.
Zuckerherstellung
Die Herstellung des modifizierten Zuckers hat die Forschenden Jahre gekostet, aber die organische Synthese des sogenannten Pseudaminsäure-Derivats war entscheidend für die Forschungsarbeit. „Prinzipiell könnte man den Zucker aus den Bakterien isolieren. Das wäre aber sehr aufwändig und die Mengen wären zu gering“, so Werz. Außerdem sollte der Zucker chemisch so umgebaut werden, dass er leicht mit einem fluoreszierenden Farbstoff reagiert.
Experimente mit Zucker und Bakterien
Bakterien bilden eine schützende Hülle aus, indem sie Zucker aufnehmen oder ihn selbst herstellen. Der Zucker wird dann vom Bakterium auf seiner Oberfläche präsentiert. Kennzeichnend für eine bestimmte Gruppe von Bakterien, die für den Menschen gefährlich sind, können gewisse Zucker sein. Solche Bakterien können also über die Zuckermoleküle, die sie aufnehmen und einbauen, identifiziert werden. Professor Fridman konnte das nachzuweisen, indem er zwei Bakterienarten – Campylobacter jejuni und Bacillus thuringiensis – getestet hat, die den entsprechenden Zucker auf ihrer Oberfläche präsentieren. Nach der Zugabe eines Fluoreszenz-Farbstoffs hat der Zucker reagiert und den Farbstoff gebunden, wodurch die Bakterien detektiert werden konnten. „Zwei andere Arten von Bakterien, die den Zucker nicht exprimieren, wurden als Kontrolle verwendet“, so Fridman.
Nutzen für die Antibiotika-Entwicklung
Anstatt gefährliche Bakterien zu töten, weiß man inzwischen, dass es reicht, ihre Virulenzfaktoren auszuschalten und sie so unschädlich zu machen. Die von den beiden Gruppen entwickelte Methode erlaubt die Detektion dieses mit der Virulenz assoziierten Zuckers. Die Methode ermöglicht es somit, neuartige Medikamente zu testen, die die Herstellung dieses Zuckers in den Bakterien und damit die krankmachende Wirkung dieser Mikroorganismen verhindern.
Quelle: Informationsdienst Wissenschaft